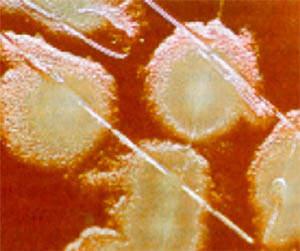
Устойчивый к антибиотикам штамм золотистого стафилококка — MRSA (фото с сайта www.ironhoof.fslife.co.uk)

Хирург и специалист по инфекционным заболеваниям Марк Шпигельман (Mark Spigelman) из Университетского колледжа в Лондоне (University College London) считает, что повышенные требования к гигиене в хирургических клиниках парадоксальным образом способствуют распространению внутрибольничных инфекций, в частности устойчивых к метициллину штаммов золотистого стафилококка (MRSA).
Устойчивые к большинству антибиотиков штаммы золотистого стафилококка — бактерии MRSA (methicillin resistant Staphylococcus aureus) — стали настоящим бичом больниц и госпиталей. Несмотря на все усилия, вывести инфекцию не удается. В 2003-04 гг. 40% случаев заражения крови в Великобритании было связано с MRSA. Вне больниц бактерия, как правило, теряет активность. Однако в последнее время всё чаще отмечаются случаи, когда инфекция выходит за пределы медицинских учреждений.
В дискуссионной статье, опубликованной в журнале Annals of The Royal College of Surgeons of England профессор Марк Шпигельман указывает на два принципиальных факта, которые, с его точки зрения, объясняют неэффективность борьбы с инфекцией MRSA в больницах:
1. Избыточные меры гигиены, применяемые в больницах, особенно в хирургических отделениях, уничтожают безвредные бактерии, создавая тем самым среду для заселения бактериями MRSA.
2. Применение антибиотиков в гигиенических целях, в частности использование антибактериального мыла, не только ведет к появлению устойчивых к антибиотикам штаммов, но и активизирует у бактерий защитные механизмы, которые в менее агрессивной среде не действуют.
Вне больниц бактериям MRSA жить значительно труднее, так как приходится конкурировать со множеством других микроорганизмов. В то же время, уникальные приспособительные механизмы MRSA предназначены именно для противостояния антибиотикам.

Из этих тезисов довольно естественно следуют меры по борьбе с инфекцией. Прежде всего, надо разделить больницы на два типа — те, где используются антибиотики, и те, где они не применяются. В первую очередь это касается хирургии. Разделение должно быть очень жестким. Персонал не должен совмещать работу в больницах разного типа. При необходимости использовать антибиотики в клинике, где они запрещены, больной должен переводиться в другое медицинское учреждение.
Но, пожалуй, самое неожиданное предложение Марка Шпигельмана — существенно изменить гигиенические процедуры. С середины XVIII века, когда была понята необходимость гигиены в медицине, требования к ней постоянно повышались. Сейчас хирурги перед операцией не только тщательно моют руки, но и скребут их, используя при этом антисептики. Тем самым, наряду с опасными, уничтожаются безвредные микробы-симбионты и освобождается место для других бактерий, таких как MRSA. Это обратная сторона доведенных до предела гигиенических процедур.
Автор считает, что пришло время пересмотреть подходы к медицинской гигиене. В частности, он пишет, что вместо антибиотиков при подготовке к операции стоит попробовать использовать пробиотики — микробные культуры, способные противостоять болезнетворным бактериям. Образно говоря, хирургу надо мыть руки не антисептическим мылом, а йогуртом.
Конечно, мнение Марка Шпигельмана не следует воспринимать как доказанную научную истину — это пока лишь предложение, высказанное в дискуссионной статье. Однако приведенные в ней соображения наверняка заинтересуют многих врачей.



